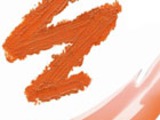

Опубликовала myCharm: Юлия Гнедина
в группе Новости красоты
Оранжевый тренд
Продукты морковного цвета – на пике своей популярности. Этот цвет присутствует во многих весенних и летних коллекциях. И если поначалу оранжевая подводка или апельсиновые губы кажутся вам чем-то «из ряда вон», то, посмотрев на продукты, которые предлагают мировые бренды, многие сомнения могут развеяться.
Это, конечно, смело, но согласитесь, образ получается необыкновенно ярким и незабываемым. Оранжевый цвет весной 2010-го может быть неоново-светящимся, кораллово-красным или сочным морковным.
Оранжевый лак для ногтей можно встретить часто в весеннее-лентих гаммах, к примеру, в летней коллекции MAC. Здесь этот оттенок прям какой-то флуоресцентный, очень жаркий!


Этот оранжево-красный «обжигает», да ещё и вдохновляет на новые шедевры)))

А вот для осени 2010 Gucci предлагает тоже оранж, но уже насыщенный по тону и металлизированный.

Настоящий «пожар в джунглях» эта подводка от MAC.


А вот оранжевые продукты от Make Up For Ever:

Здесь: блеск для губ в тюбике, пудра, карандаш.
Текстуры и оттенки оранжевого согревают и завораживают, правда?

И, конечно, оранжево-красный или морковный на губах – вечный тренд, вечная молодость!

Фото коллекции Лето-2010 от Estee Lauder (Bronze Goddess)

Показ Herve Leger (Fall-2010)
Это, конечно, смело, но согласитесь, образ получается необыкновенно ярким и незабываемым. Оранжевый цвет весной 2010-го может быть неоново-светящимся, кораллово-красным или сочным морковным.
Оранжевый лак для ногтей можно встретить часто в весеннее-лентих гаммах, к примеру, в летней коллекции MAC. Здесь этот оттенок прям какой-то флуоресцентный, очень жаркий!


Этот оранжево-красный «обжигает», да ещё и вдохновляет на новые шедевры)))

А вот для осени 2010 Gucci предлагает тоже оранж, но уже насыщенный по тону и металлизированный.

Настоящий «пожар в джунглях» эта подводка от MAC.


А вот оранжевые продукты от Make Up For Ever:

Здесь: блеск для губ в тюбике, пудра, карандаш.
Текстуры и оттенки оранжевого согревают и завораживают, правда?

И, конечно, оранжево-красный или морковный на губах – вечный тренд, вечная молодость!

Фото коллекции Лето-2010 от Estee Lauder (Bronze Goddess)

Показ Herve Leger (Fall-2010)
|
2 марта 2010 года | 1519 | оставить комментарий |
| Код для вставки |
Коды для вставки:
Как это будет выглядеть?
Скопируйте код и вставьте в окошко создания записи на LiveInternet, предварительно включив там режим "Источник".
HTML-код:

|
|
| BB-код для форумов: |
Как это будет выглядеть?
myCharm.Ru → Оранжевый тренд
|
Продукты морковного цвета – на пике своей популярности. Этот цвет присутствует во многих весенних и летних коллекциях. И если поначалу оранжевая подводка или апельсиновые губы кажутся вам чем-то «из ряда вон», то, посмотрев на продукты, которые предлагают мировые бренды, многие сомнения могут развеяться. Читать полностью |














Пока нет комментариев.